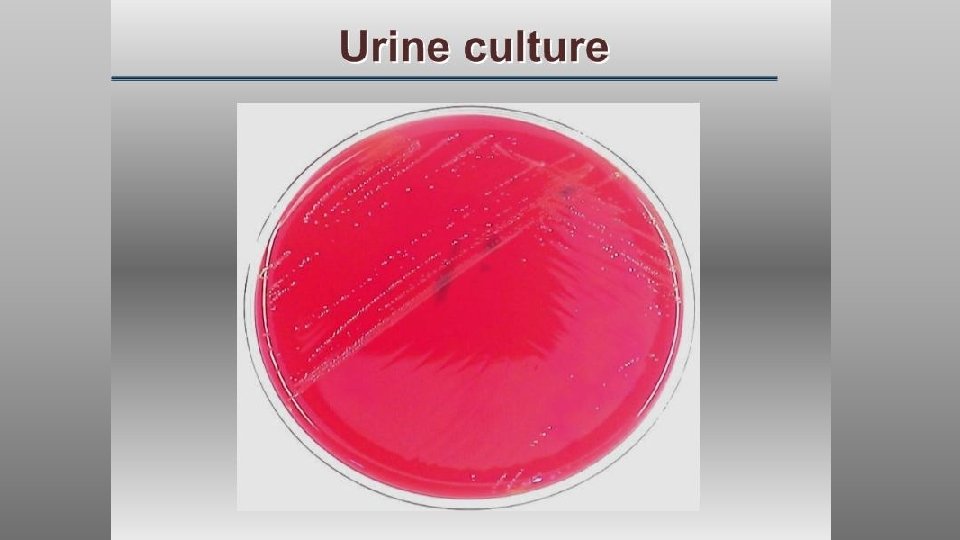

Definition The term urinary tract infection UTI usually















































- Slides: 47


Definition: • The term urinary tract infection (UTI) usually refers to the presence of organisms in the urinary tract together with symptoms, and sometimes signs, of inflammation.

It is more precise to use one of the following terms:

Significant Bacteriuria: • Defined as the presence of at least 100, 000 bacteria/m. L of urine. • Normally small numbers of bacteria are normally found in the anterior urethra and may be washed out into urine samples. • Counts of fewer than 1000 bacteria/m. L are normally considered to be urethral contaminants unless there are exceptional clinical circumstances, such as a sick immunosuppressed patient.


ØAsymptomatic Bacteriuria: • Significant bacteriuria in the absence of symptoms in the patient. ØCystitis: • Syndrome of frequency, dysuria and urgency, • Usually suggests infection restricted to the lower urinary tract, (the bladder and urethra). ØUrethral syndrome: • Syndrome of frequency and dysuria in the absence of significant bacteriuria with a conventional pathogen

ØAcute pyelonephritis: • An acute infection of one or both kidneys. • Usually, the lower urinary tract is also involved.

Chronic pyelonephritis: • IT IS confusing term used in different ways: • Continuous excretion of bacteria from the kidney, • Frequent recurring infection of the renal tissue, • Particular type of pathology of the kidney seen microscopically or by radiographic imaging, which may or may not be due to infection. ØAlthough chronic infections of renal tissue are relatively rare, they do occur in the presence of kidney stones and in tuberculosis.

Relapse and Reinfection • Relapse: is recurrence caused by the same organism that caused the original infection. • Reinfection: is recurrence caused by a different organism, and is therefore a new infection.

Aetiology and risk factors • AGE & GENDER • Causative Bacterium • Underlying Structural Abnormalities • Hospital-acquired urinary infections

AGE & GENDER • UTI is a problem in all age groups. • In infants up to the age of 6 months… much more common in boys than in girls. • In preschool children and adult … the prevalence is more in girls. • In the elderly, the prevalence of bacteriuria rises dramatically in both sexes.

Causative Bacterium • (80%) Escherichia coli is the most common • (20%) Gram-negative enteric bacteria such as Klebsiella and Proteus species, and by Grampositive cocci, particularly enterococci and Staphylococcus saprophyticus. • Rare causes: anaerobic bacteria and fungi • Viruses (in immunocompromised patients, particularly children)

Underlying Structural Abnormalities • Congenital anomalies, • Neurogenic bladder, • Obstructive uropathy, is often caused by more resistant organisms such as • Pseudomonas aeruginosa, • Enterobacter and Serratia species

Acquired • Hospital-acquired urinary infections, • Including those in patients with urinary catheters.

Pathogenesis • There are three possible routes by which organisms might reach the urinary tract: • The Ascending, • Blood-borne, • Lymphatic routes.


Why women more than men? 1. The urethra in women is shorter than in men, 2. The urethral meatus is closer to the anus, 3. Further, sexual intercourse appears to be important in forcing bacteria into the female bladder, 4. The risk is increased by the use of diaphragms and spermicides, which have both been shown to increase E. coli growth.

Natural defence mechanisms üHigh urea concentration and üExtremes of osmolality and p. H inhibit pathologic growth. üThe flushing mechanism of bladder emptying, üThe bladder mucosa, by virtue of a surface glycosaminoglycan, is intrinsically resistant to bacterial adherence. q. If infection occur---WBC are mobilized to the bladder surface to ingest and destroy invading bacteria.

Abnormalities of the urinary tract ØStructural abnormality leading to the obstruction of urinary flow increases the likelihood of infection. • Such abnormalities: • Congenital anomalies of the ureter or urethra, • Renal stones and, • Enlargement of the prostate (in men). ØRenal stones can become infected with bacteria, particularly Proteus and Klebsiella species, and thereby become a source of ‘relapsing’ infection.

Vesicoureteric reflux (VUR) • Is a condition caused by failure of physiological valves at the junction of the ureters and the bladder which allows urine to reflux towards the kidneys when the bladder contracts. • It is probable that VUR plays an important role in childhood UTIs that lead to chronic renal damage (scarring) and persistence of infection.


Clinical manifestations ØBabies and infants • Failure to thrive, vomiting, fever, diarrhoea and apathy • Misdiagnosed because the signs may not be referable to the urinary tract. ØPrognosis: • Renal scarring, • Chronic pyelonephritis in adulthood, • Hypertension and • Renal failure.

Clinical manifestations ØChildren • Classic symptoms such as frequency, dysuria, haematuria. • Acute abdominal pain and vomiting

Clinical manifestations ØAdults § Lower UTI • Frequency, Dysuria, Urgency, Haematuria. § Acute pyelonephritis (upper UTI) • Fever, Rigors and Loin Pain in addition to lower tract symptoms. • Systemic symptoms may vary from insignificant to extreme malaise. , ØUntreated cystitis in adults rarely progresses to pyelonephritis, and bacteriuria does not seem to carry the adverse long-term consequences that it does in children.

Clinical manifestations ØElderly • UTI is one of the most frequent causes of admission to hospital. • Majority of cases are asymptomatic. • Symptoms are not diagnostic because frequency, dysuria, hesitancy and incontinence are common in elderly people without infection. • The infection may be the cause of deterioration in pre-existing conditions such as diabetes mellitus or congestive cardiac failure.

Investigations • The key to successful laboratory diagnosis of UTI lies in obtaining an uncontaminated urine sample for microscopy and culture. • Specimens must reach the laboratory within 1– 2 h or should be refrigerated; otherwise, any bacteria in the specimen will multiply and might give rise to a false-positive result.

Dipsticks

Microscopy

Treatment • Symptomatic UTI usually merits antibiotic treatment to eradicate both symptoms and pathogen. • Asymptomatic bacteriuria may or may not need treatment depending upon the circumstances of the individual case. • Bacteriuria in children and in pregnant women requires treatment, as does bacteriuria present when surgical manipulation of the urinary tract is to be undertaken, because of the potential complications.

Non-specific treatments • Drink a lot of fluids • Frequent bladder emptying. • Urinary Analgesics such as potassium or sodium citrate, which • Alkalinise the urine, but these should be used as an adjunct to antibiotics. (but not nitrofurantoin)

Antimicrobial • Blood levels of antibiotics appear to be unimportant in the treatment of lower UTI; what matters is the concentration in the urine. • However, blood levels probably are important in treating pyelonephritis, which may progress to bacteraemia.

Treatment of Cystitis ØOral treatment include: • Trimethoprim, • β-lactams, particularly amoxicillin, co-amoxiclav and cefalexin, • Fluoroquinolones (ciprofloxacin, norfloxacin and ofloxacin), • Nitrofurantoin. ØIntravenous administration include: • β-lactams such as amoxicillin and cefuroxime, • Quinolones, • Aminoglycosides such as gentamicin.

In renal failure… • Agents of choice for treating UTI in the presence of renal failure are: • Penicillins and Cephalosporins attain satisfactory concentrations and are relatively non-toxic, • It may be difficult to achieve adequate therapeutic concentrations of some drugs in the urine, particularly nitrofurantoin and quinolones. • Further, accumulation and toxicity may complicate the use of aminoglycosides.

Antibiotic resistance • Extended-spectrum β-lactamase (ESBL-E. coli) is often pathogenic, result in bacteremia with resultant mortality… • (ESBL) bacteria producing enzymes destroy almost all commonly used β -lactams EXCEPT the carbapenem, • Most penicillins and cephalosporins largely useless in clinical practice. • Clavulanic acid is β-lactamase inhibitor, (co-amoxiclav) • ESBL Multiresistant to non-β-lactam antibiotics too, such as quinolones, aminoglycosides and trimethoprim.

Uncomplicated lower UTI ØTreatment in adult • Trimethoprim, • Oral cephalosporin such as cefalexin, • Co-amoxiclav or • Nitrofurantoin, • The quinolones are best reserved for treatment failures and more • difficult infections, • Overuse of these important agents is likely to lead to an increase in resistance.


Duration of treatment • Traditionally, a course of 7– 10 days (β-Lactams) • Short-course regimens for 3 -days (trimethoprim and quinolones). • Or even single-dose therapy. • Single-dose therapy, advantages: • Low cost, good adherence and the minimisation of side effects, • Disadvantages: • Less effective than when the same agent is used for longer.

Treatment in Children • The drugs of choice include: • β-lactams, • Trimethoprim and • Nitrofurantoin. • Quinolones are relatively contraindicated in children because of theoretical risk of causing cartilage and joint problems. • Children should be treated for 7– 10 days.

Acute pyelonephritis Ø Severely ill patient ----- • A first-choice agent would be Parenteral antibiotic: • Cefuroxime, • Gentamicin or • Ciprofloxacin. • When the patient is improving, switch to oral therapy, like Quinolone for 10– 14 days. Ø Less severely ill patient… • Oral antibiotic with a shorter course

In hospital-acquired pyelonephritis • Start with a broad-spectrum agent such as: • Ceftazidime, • Ciprofloxacin, • Meropenem. • There is a risk that the infecting organism may be resistant to the usual first-line drugs.


Relapsing UTI • The main causes of persistent relapsing UTI are: • Renal infection, • Structural abnormalities of the urinary tract and, • In men, chronic prostatitis.

Catheter-associated infections ØEven with the very best catheter care, most will have infected urine after 10– 14 days of catheterisation, ØThe principles of antibiotic therapy for catheter-associated UTI as follows: • Do not treat asymptomatic infection. • If possible, remove the catheter before treating symptomatic infection.

Bacteriuria of Pregnancy • 5% have asymptomatic bacteriuria. • A third of these women proceed to develop acute pyelonephritis. ØAsymptomatic bacteriuria is associated with: • Low birth weight, • Prematurity, • Hypertension, • Preeclampsia. ØThe drugs of choice are amoxicillin or cefalexin or nitrofurantoin, 7 days of treatment

Prevention and prophylaxis • Adult only • long-term, low dose (Once) of: • Trimethoprim (100 mg) or • Nitrofurantoin (50 mg) at night will suffice.

Thank you